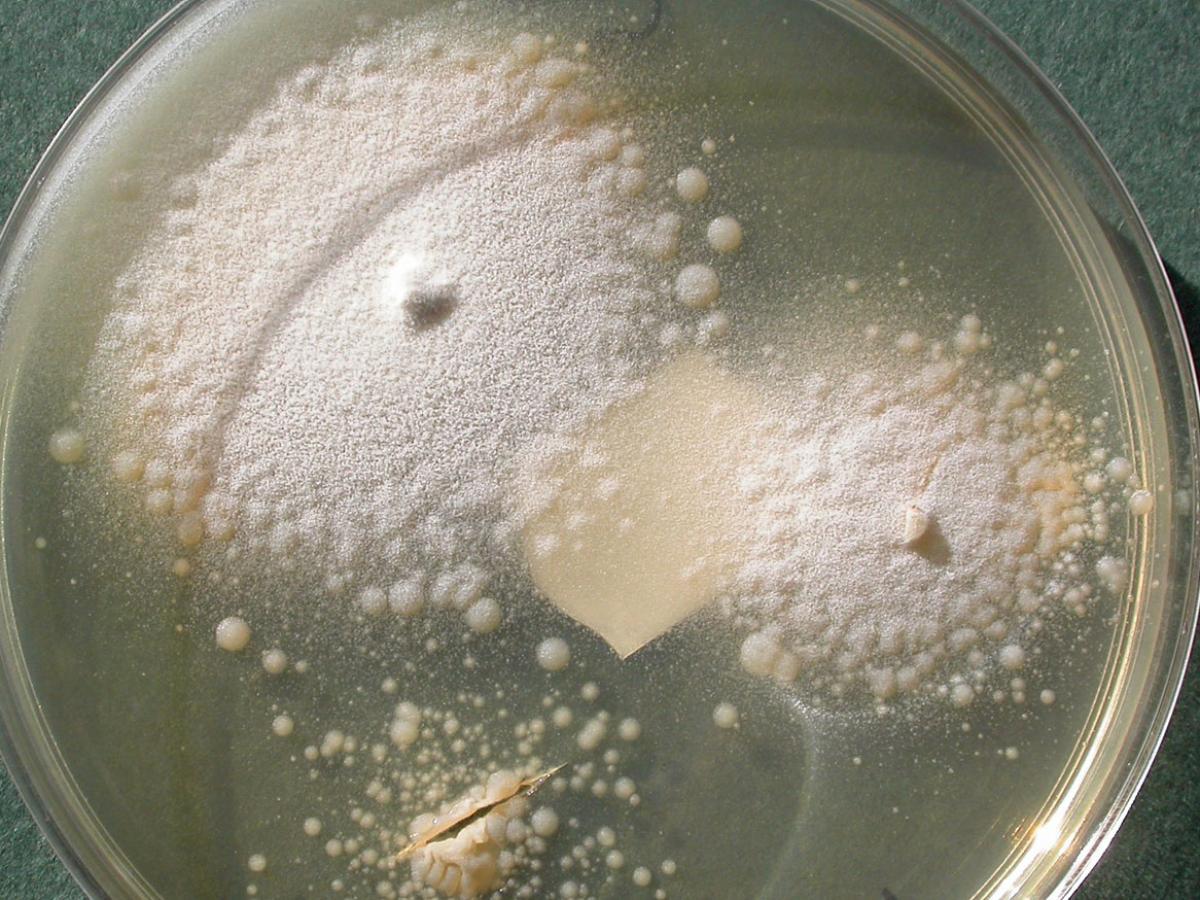
Culture

Status message
Correct! Excellent, you have really done well. Please find additional information below.
Unknown 19 = Conidiobolus coronatus
Culture: Colonies grow rapidly and are flat, cream coloured, glabrous, becoming radially folded and covered by a fine, powdery, white surface mycelium and conidiophores. The lid of the petri dish soon becomes covered with conidia, which are forcibly discharged by the conidiophores. The colour of the colony may become tan to brown with age.
Note the numerous satellite colonies due to discharged conidia.
Microscopy: Conidiophores are simple, forming solitary, terminal conidia which are spherical, 10-25 um in diameter, single-celled and have a prominent papilla. Conidia may also produce hair-like appendages called villae. Conidia germinate to produce either, (1) single or multiple hyphal tubes that may also become conidiophores which bear secondary conidia, or (2) produce multiple short conidiophores, each bearing a small secondary conidium.



Comment: Entomophthoromycosis caused by Conidiobolus sp. is a chronic inflammatory or granulomatous disease that is typically restricted to the nasal submucosa and characterised by polyps or palpable restricted subcutaneous masses. Infections also occur in horses usually producing extensive nasal polyps and other animals. Conidiobolus coronatus is also a recognised pathogen of termites, other insects and spiders.
About Conidiobolus Back to virtual assessment